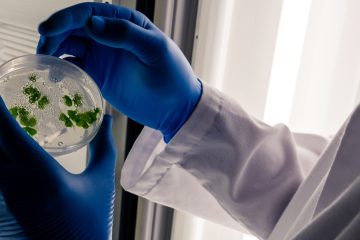
руки лаборанта в синих перчатках держат чашку Петри с растениями

Здравствуйте! С вами Сергей. Надеюсь, слова про науку вас не сильно испугали, ведь в этой статье я хочу рассказать,...
Обработка растений в ночное время световыми волнами определённой длины может стать эффективным средством против вредителей и болезней растений.
Подробно рассказываем о процессе выращивания микрозелени бурого гороха. Тестируем набор для выращивания микрозелени, проверяем на прочность бумажный лоток.
Здравствуйте, на связи Сергей. В некоторых своих статьях я мог упомянуть о чём-то с обещанием рассказать про это подробнее...
Пошаговая инструкция по выращиванию микрозелени кресс-салата. Необходимые материалы, технология выращивание и сравнение двух субстратов: торфяного и кокосового
Здравствуйте! С вами Сергей, и после короткого перерыва предлагаю вернуться к теме регуляторов роста растений — фитогормонов. Я уже рассказывал...
Рассказываем о терракотовых шариках, которые используются в качестве субстрата для гидропоники, дренажа, декора и других целей
Если покупка дачи у вас ещё только в планах, но тяга к садоводству очень сильна, поступайте так, как...
Рассматриваем свойства абсцизовой кислоты — фитогормона, который регулирует многие аспекты жизни растения и помогает приспособиться к неблагоприятным условиям
Здравствуйте, с вами Сергей, и мы продолжаем разговор о гормонах и стимуляторах роста растений. Вещество, о котором сегодня...
Всем привет, на связи Сергей, и мы продолжаем нашу интересную беседу о микроклональном размножении растений. Больше материалов по...
Гиббереллиновая кислота стимулирует рост растений, играет важную роль во многих процессах. Рассказываем, как с помощью этого фитогормона можно увеличить урожаи.